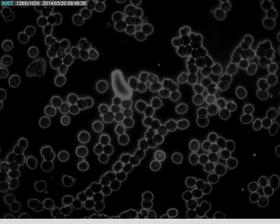
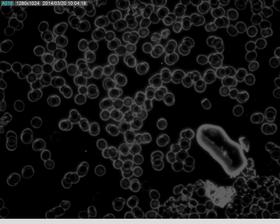
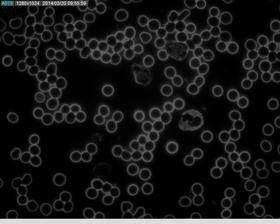

naturopat
20. mar 2014
Fotky z darkfield mikroskopu
V tmavom poli mikroskopu je možné pozorovať stav organizmu - kondíciu červených a bielych krviniek, preťaženie obličiek a pečene, disbiózu v črevách, oslabenie imunity, autoimunitné poruchy, alergie, ťažké kovy a chemikálie. Dáva komplexný obraz o stave organizmu. Na základe toho je možné aj odporučiť zmenu stravovania a nastaviť hĺbkovú detoxikáciu ušitú na mieru. Vyplavovanie metabolického odpadu, ťažkých kovov z tkanív je možné sledovať pri pravidelnej kontrole každé 3-4 mesiace.

zaujímavé